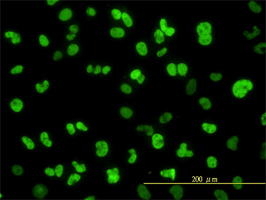

Filters
Clonality
Type
Reactivity
Gene Name
Isotype
Host
Application
Clone
576 results for " expressed in human cell line 293" - showing 350-400
GSR, Monoclonal Antibody (Cat# AAA25707)
PGM1, Monoclonal Antibody (Cat# AAA25198)
ALS2CR8, Monoclonal Antibody (Cat# AAA24432)
SARS, Monoclonal Antibody (Cat# AAA24944)
CSTF3, Monoclonal Antibody (Cat# AAA24180)
MRPL12, Monoclonal Antibody (Cat# AAA25461)
UGP2, Monoclonal Antibody (Cat# AAA24696)
ARID3A, Monoclonal Antibody (Cat# AAA24434)
KAP-1, Monoclonal Antibody (Cat# AAA25729)
NQO1, Monoclonal Antibody (Cat# AAA25475)
PAX5, Monoclonal Antibody (Cat# AAA25484)
TAF7, Monoclonal Antibody (Cat# AAA24975)
ARID3A, Monoclonal Antibody (Cat# AAA24729)
ARNT, Monoclonal Antibody (Cat# AAA24730)
FOXA2, Monoclonal Antibody (Cat# AAA24216)
SARS, Monoclonal Antibody (Cat# AAA25240)
UGP2, Monoclonal Antibody (Cat# AAA24993)
ATP2C1, Monoclonal Antibody (Cat# AAA24734)
RBM9, Monoclonal Antibody (Cat# AAA25519)
OCRL, Monoclonal Antibody (Cat# AAA25775)
RAD18, Monoclonal Antibody (Cat# AAA25516)
NQO1, Monoclonal Antibody (Cat# AAA25771)
GSR, Monoclonal Antibody (Cat# AAA24230)
PGM1, Monoclonal Antibody (Cat# AAA25788)
RBM9, Monoclonal Antibody (Cat# AAA14778)
Purified by Protein A affinity chromatography.
TOMM22, Monoclonal Antibody (Cat# AAA25277)
DARS, Monoclonal Antibody (Cat# AAA24776)
POLK, Monoclonal Antibody (Cat# AAA25802)
CAPNS1, Monoclonal Antibody (Cat# AAA25043)
MRPL12, Monoclonal Antibody (Cat# AAA24279)
RBM9, Monoclonal Antibody (Cat# AAA25815)
CBS, Monoclonal Antibody (Cat# AAA25044)
KAP-1, Monoclonal Antibody (Cat# AAA24547)
Survivin, Monoclonal Antibody (Cat# AAA25562)
TAF7, Monoclonal Antibody (Cat# AAA25565)
SARS, Monoclonal Antibody (Cat# AAA25830)
OCRL, Monoclonal Antibody (Cat# AAA24297)
LDB3, Monoclonal Antibody (Cat# AAA24551)
FOXA2, Monoclonal Antibody (Cat# AAA24807)
PAX5, Monoclonal Antibody (Cat# AAA24302)
UGP2, Monoclonal Antibody (Cat# AAA25582)
CSTF3, Monoclonal Antibody (Cat# AAA25068)
Survivin, Monoclonal Antibody (Cat# AAA25858)
NDUFS4, Monoclonal Antibody (Cat# AAA24581)
TAF7, Monoclonal Antibody (Cat# AAA25861)
AGP1, Monoclonal Antibody (Cat# AAA25603)
TARDBP, Monoclonal Antibody (Cat# AAA25862)
ENO3, Monoclonal Antibody (Cat# AAA24080)
Purified by Protein A affinity chromatography.